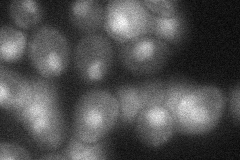
YNL215W
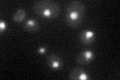
YNL215W

View description
Protein that associates with the INO80 chromatin remodeling complex under low-salt conditions; essential for growth under anaerobic conditions
Localization:
Intensity:
Fold change:
Significance:
-
C’ GFP library in SD

nucleus32.9 -
N' NOP1pr-GFP in SD

nucleus89.8278 -
N' TEF2pr-mCherry in SD

nucleus418.097 -
N' NATIVEpr-GFP in SD

nucleus34.8803 -
N' TEF2pr-VC and Cyto-VN in SD
nucleus35.7968 -
C’ GFP library in SD+DTT

nucleus37.081.12No -
C’ GFP library in SD+H2O2

nucleus30.790.93No -
C’ GFP library in Starvation Media
nucleus47.491.44Yes -
C’ GFP library on the background of Pup2-DaMP

nucleus -
C’ GFP library on the background of CCT mutant

nucleus29.63760.900406No
